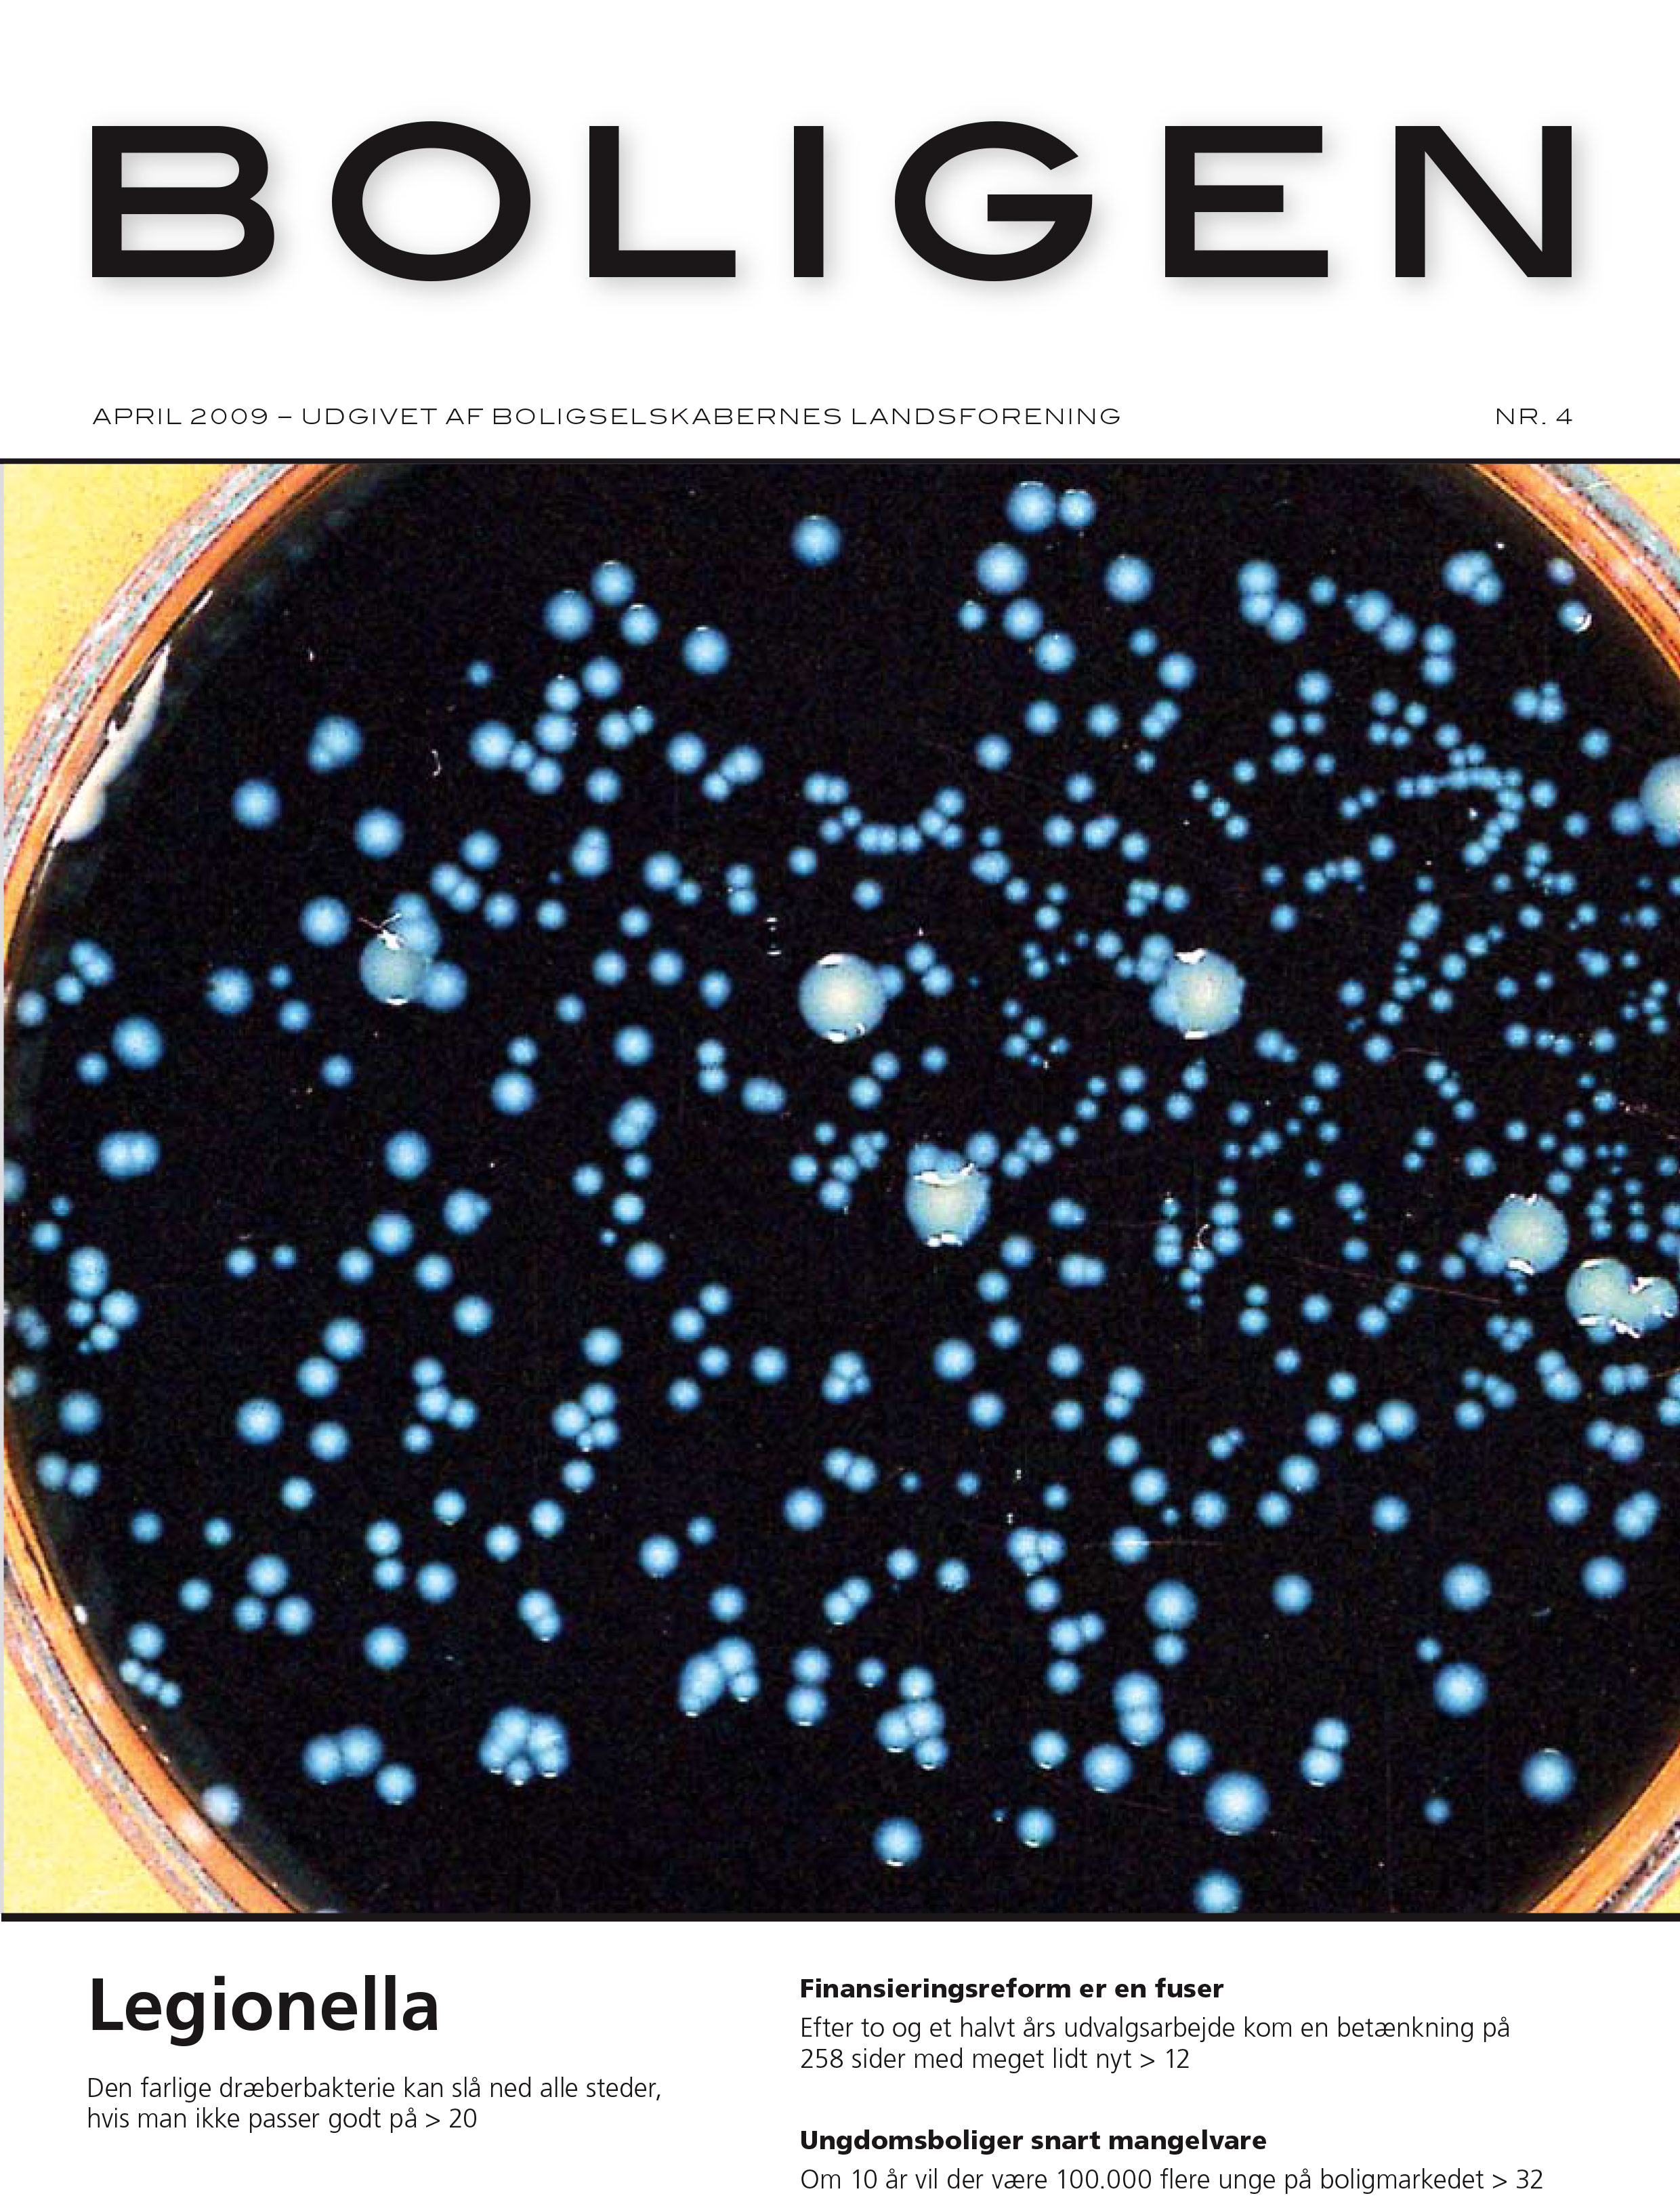
boligen-nr-4-2009.jpg

Boligen arkiv
Boligen er siden 1933 udkommet som et månedsblad. I 1933 var et månedsblad en tidssvarende og velfungerende nyhedsformidler. Sådan er det ikke mere, de trykte nyhedsmedier er blevet overhalet af netmedierne, og derfor udkom Boligen på tryk for sidste gang i efteråret 2019. Boligen har en lang historie, og vi har gemt alle vores blade digitalt, og du kan dykke ned i vores store digitale arkiv.
Søg i Arkivet
Januar 1933, Boligen nr. 1
2019
2018
2017
2016
2015
2014
2013
2012
2011
2010
2009
2008